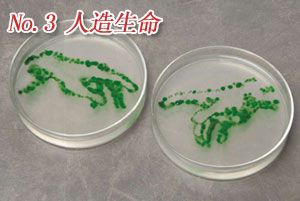

新浪科技讯 北京时间7月12日消息,据国外媒体报道,美国科学家已成功研制出“人造血”,最快能在5年内用于救治在战场上受伤的美军士兵。
他们采用基因工程技术,从脐带中提取细胞,利用机器模拟骨髓造血机制,产生大量可用红血球,由此造出人造血。这个项目名为“血液嫁接”(blood pharming),是由五角大楼下属研究机构——国防高级研究计划局(DARPA)于2008年发起,旨在造血用以治疗偏远战场上的美军士兵。因“人造血”项目而获得195万美元研究经费的Arteriocyte公司已将其制造的首批O型阴性血样本送至美国食品药品管理局鉴定。
人造血是通过一个名为“嫁接”的过程,由取自脐带的造血细胞生成。所谓“嫁接”是指利用转基因植物或动物制造大量可用物质。一条脐带最终可以转换为大约20个单位的可用血液。在战场上,每个伤兵在治疗中需要平均6个单位的血液。Arteriocyte公司宣称,采用这种技术制造的血细胞的功能“与健康人体循环中的红血球无异。”
该公司老板布朗在接受《连线》杂志采访时说:“我们基本上可以在实验室环境中模拟骨髓的造血功能。我们的模型是奏效了,但我们需要提升生产能力以形成规模。”倘若这种人造血获得批准,将为战场伤兵治疗带来全面革新。在战场上,由于捐血者不足,常常对伤兵的治疗带来种种问题。
在战区运输血液更为困难,因为捐献的血液必须经过长途跋涉才能到达急需血液的战地医院。血液的“保鲜期”通常为四周,依照现有程序,民众捐血到把血液送到美军最偏远的单位,最快需要21天,也就是说,必须要在7天内将其用完,否则只能丢弃。如果血液超过四周的期限,士兵出现感染或器官功能衰竭的风险会增加。
布朗说:“在此之前,由于基本上只能使用不新鲜的血液,军方的战略已经受到严重的牵制。他们计划在战区建立移动血库,但如果遇到危机,有大量士兵受伤,即便是整支部队人员都出来捐血,仍然不够。”
这种人造血最快要到2013年才能进行人体实验,但Arteriocyte预测,只要美国国防部尽快提出要求,美军有望在5年内使用人造血治疗伤兵。1个单位的人造血量约为1品脱(约合473毫升),人体共有8至10品脱血液。目前,Arteriocyte每制造1单位的人造血,造价5000美元;倘若获得通过,Arteriocyte可通过增加产量将成本降至1单位1000美元左右。
除了满足军方需要,人造血也可能在医院面临血荒时助其一臂之力。Arteriocyte的人造血是O型阴性血,这也是最紧缺的血型,因为它可用于治疗各种患者,无论他们是什么样的血型。今年6月,美国红十字会紧急呼吁公众踊跃捐血,因为他们的O型阴性血的库存“处于严重不足的水平”。 |